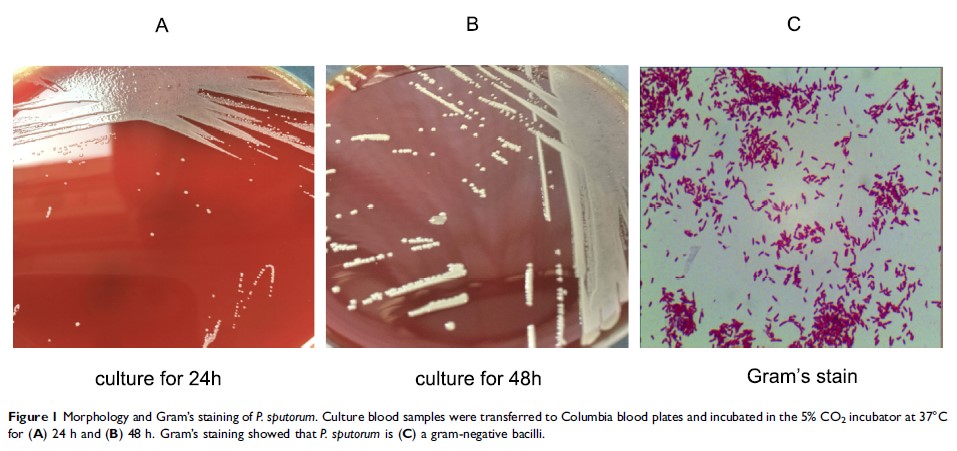

论文已发表
注册即可获取德孚的最新动态
IF 收录期刊
Case Report
曾接受异基因肝移植及免疫抑制治疗的患者的潘多拉孢子菌菌血症:一份病例报告
Review
大便潜血试验用于检测近端与远端结肠直肠肿瘤形成的诊断准确性:系统评价和荟萃分析

Original Research 简明总结
Single-Use Autoinjector Functionality And Reliability For At-Home Administration Of Benralizumab For Patients With Severe Asthma: GRECO Trial Results

Original Research
ANGPTL3 基因遗传变异与缺血性中风易感性的关联研究

Original Research
合成有很高驰豫效果的 PEG 包覆、超小锰掺杂的氧化铁纳米粒子用于 T1/T2 双对比度磁共振成像

Original Research
青年乳腺癌患者术前血清 CEA 和 CA125 水平及诺模图的预后价值
